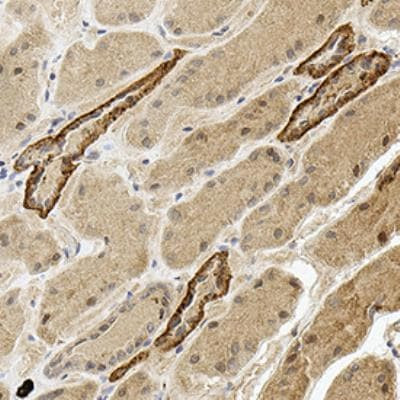
PDZD3 Antibody in Immunohistochemistry (Paraffin) (IHC (P))

Search
Invitrogen
PDZD3 Polyclonal Antibody
{{$productOrderCtrl.translations['antibody.pdp.commerceCard.promotion.promotions']}}
{{$productOrderCtrl.translations['antibody.pdp.commerceCard.promotion.viewpromo']}}
{{$productOrderCtrl.translations['antibody.pdp.commerceCard.promotion.promocode']}}: {{promo.promoCode}} {{promo.promoTitle}} {{promo.promoDescription}}. {{$productOrderCtrl.translations['antibody.pdp.commerceCard.promotion.learnmore']}}
图: 1 / 2
PDZD3 Antibody (PA3-16819) in IHC (P)


产品信息
PA3-16819
种属反应
已发表种属
宿主/亚型
分类
类型
抗原
偶联物
形式
浓度
保存液
内含物
保存条件
运输条件
RRID
产品详细信息
This antibody is not recommended for ICC/IF applications.
靶标信息
Acts as a regulatory protein that associates with GUCY2C and negatively modulates its heat-stable enterotoxin-mediated activation.
仅用于科研。不用于诊断过程。未经明确授权不得转售。
生物信息学
蛋白别名: DLNB27; IKEPP scaffold protein; intestinal and kidney enriched PDZ protein; Intestinal and kidney-enriched PDZ protein; Na(+)/H(+) exchange regulatory cofactor 4; Na(+)/H(+) exchange regulatory cofactor NHE-RF4; Na/Pi cotransporter C-terminal-associated protein 2; naPi-Cap2; Natrium-phosphate cotransporter IIa C-terminal-associated protein 2; NHERF-4; PDZ domain containing 2; PDZ domain containing 3; PDZ domain-containing protein 2; PDZ domain-containing protein 3; Sodium-hydrogen exchanger regulatory factor 4; sodium-phosphate cotransporter IIa C-terminal-associated protein 2; unnamed protein product
基因别名: DLNB27; IKEPP; NaPi-Cap2; NHERF4; PDZD3; PDZK2; RGD1559807
UniProt ID: (Human) Q86UT5, (Mouse) Q99MJ6
Entrez Gene ID: (Human) 79849, (Mouse) 170761, (Rat) 500986